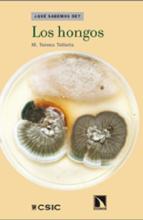

Juli G. Pausas, 2012

Isabel Varela Nieto y Luis Lassaletta Atienza, 2012

Francisco Javier Cudeiro Mazaira, 2012

Salvador Martínez Pérez, 2011

Álvaro Giménez, 2012

José Manuel López Nieto, 2011

Bernardo Herradón García, 2011

David Martín de Diego, 2011

Karel H.M. van Wely, 2011

Mª Victoria Moreno-Arribas, 2011
M. Teresa Tellería, 2011

Joan Martí Molist, 2011

Teresa de los Arcos e Isabel Tanarro, 2011

Antonio Bello, Concepción Jordá y Julio César Tello, 2010

Pilar Goya y Mª Isabel Martín, 2011

Javier López Facal, 2010

Alfonso V. Carrascosa, 2011

Juan Lerma, 2010

Javier Cilleruelo y Antonio Córdoba, 2010

Alberto Casas, 2010